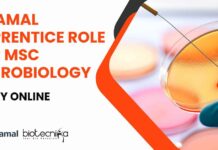
Piramal Apprentice MSc Microbiology

Home 2024
Yearly Archives: 2024
Postponement of the Joint CSIR-UGC-NET Examination June-2024
CSIR NET June Postponed 2024 - CSIR UGC NET Exam June 2024 Postponed
PUBLIC NOTICE
21.06.2024
Postponement of the Joint CSIR-UGC-NET Examination June-2024
This is in continuation...
Biotecnika Times Newsletter 21.06.2024 – CIAB Fellowships, Piramal, Colgate-Palmolive, Probiota Hiring, MIRM Admissions, IISc...
CIAB Fellowships For Microbiology, Biotech & Life Sciences - Attend Walk-In-Interview
CIAB is offering fellowships in Microbiology, Biotech, and Life Sciences. Attend the walk-in interview...
Piramal BSc & MSc Microbiology Executive Job Opening – Appy Now
Piramal Microbiology Executive Job Opening - Apply Now
Senior Executive-Microbiology
Ahmedabad, Gujarat, India
JOB DESCRIPTION
Microbial analysis of water.
Microbial testing of samples.
Environmental Monitoring.
Maintenance of...
Dr. Reddy’s Laboratories Ltd. Clinical Research Associate Recruitment – Apply Now
Dr Reddy's Clinical Research Associate Recruitment - Apply Now
Dr Reddy's Clinical Research Associate Recruitment - Apply Now. Interested and eligible applicants can check out...
Piramal Apprentice Role For MSc Microbiology – Apply Online
Piramal Apprentice MSc Microbiology - Apply Online
Apprentice
Ahmedabad, Gujarat, India
JOB DESCRIPTION
Microbial analysis of water.
Microbial testing of samples.
Environmental Monitoring.
Maintenance of microbial cultures.
...
Colgate-Palmolive Biochemistry Jr. Analyst Hybrid Job Opportunity – Apply Now!
Colgate-Palmolive Biochemistry Vacancy - Apply Now For Jr. Analyst Role
Job Title: Jr. Analyst-Supplier Compliance
Travel Required?: No Travel
Date: Jun 20, 2024
Hybrid
No Relocation Assistance Offered
# 161053...
Exciting Business Development Executive Opportunity at Wipro! BSc & MSc Life Sciences Apply
Wipro Life Sciences BDE Job Opening For BSc & MSc, Apply Now
Business Development Executive
Bengaluru, Karnataka, India
About the job
Company Description
Wipro Limited is a leading technology...
Clinical Data Analytics Lead Position at Johnson & Johnson – Apply Now!
Clinical Data Analytics Lead Position at Johnson & Johnson - Apply Now!
Job Description - Clinical Data Analytics & Reporting Lead - Mumbai / Bangalore...
Indian Institute of Petroleum and Energy Bioinformatics, Life Sciences & Biotechnology – Apply Now
IIPE Bioinformatics Research Project Job - Applications Invited Now
Ref No: IIPE/R&D/926/ICMR-02 Date: 19-06-2024
Senior Research Fellow Under ICMR funded Research Project
Applications are invited from motivated...
NIPER Life Sciences Technical Officer Job Opening – Apply Online Now
NIPER Life Sciences Technical Officer Job Opening - Apply Online Now
Recruitment for the Bio-NEST NIPER-Guwahati Incubation Centre
Advt. No: NIPERG/Admin/Bio-NEST/Rect./03(c)/2024
Dated: 13.06.2024
NIPER-Guwahati is the only...
CIAB Fellowships For Microbiology, Biotech & Life Sciences – Attend Walk-In-Interview
CIAB Fellowships For Microbiology, Biotech & Life Sciences - Attend Walk-In-Interview
CIAB Fellowships For Microbiology, Biotech & Life Sciences - Attend Walk-In-Interview. Interested and eligible...
Anatomic Pathologist for a Postdoctoral Research Fellowship at Mayo Clinic, Apply Now
Postdoctoral Research Fellowship at Mayo Clinic, Apply Now
Anatomic Pathologist for a Postdoctoral Research Fellowship
Mayo Clinic, Rochester, Minnesota (USA). Announcing a fully-funded Research Fellow position...
Biotecnika Times Newsletter 20.06.2024 – Govt Jobs at Silk Board & PMBI, Exclusive Walk-In-Drive...
Govt Central Silk Board BSc & MSc Life Sciences Project Job - Attend Walk-In-Interview
Exciting job opening at Govt Silk Board for BSc and MSc...
Hindustan Coca-Cola Beverages QA Executive Job For MSc Microbiology – Apply Online
HCCB MSc Microbiology QA Executive Job - Apply Online Now
Executive - Quality Assurance (19908)
Supply Chain
Wada Plant (11650200)
Job Description
To ensure all the products manufactured and...
Life Science Trainee Scientific Writer Job at Sanofi – Apply Online Now
Life Science Trainee Scientific Writer Job at Sanofi - Apply Online Now
Trainee Scientific Writer
Locations Hyderabad
Time type Full time
Posted on Posted Yesterday
Job Requisition ID R2747401
Our Team:
Sanofi...